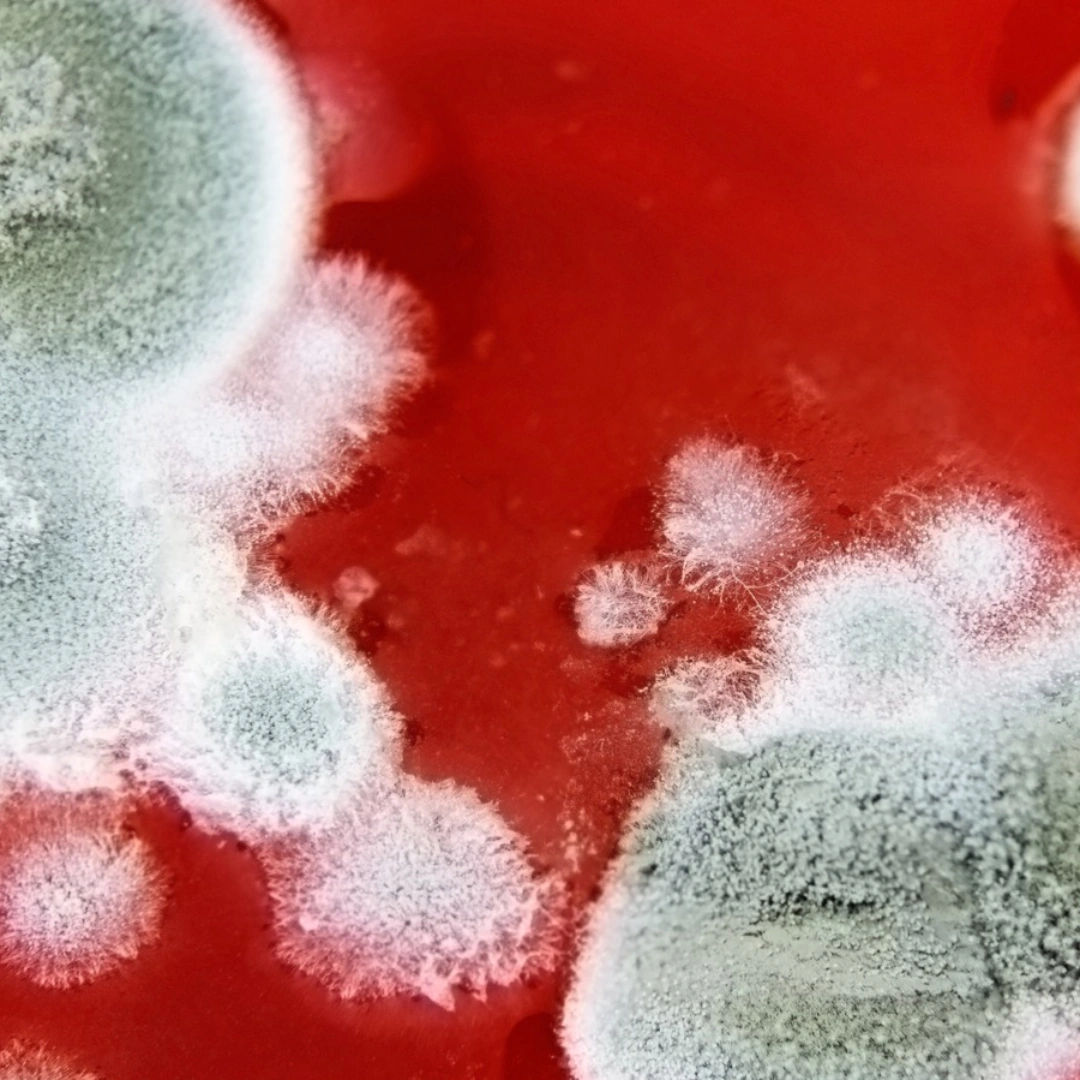

Hematocrit, Whole Blood
What it is
The Hematocrit (Hct) test measures the proportion of red blood cells (RBCs) in whole blood. It is expressed as a percentage of the total blood volume and is a key marker of overall blood health. Red blood cells carry oxygen throughout the body, so abnormal hematocrit values can signal anemia, dehydration, polycythemia, or other medical conditions.
Uses
This test is used to:
- Screen for anemia and other red blood cell disorders.
- Assess hydration status (low in overhydration, high in dehydration).
- Evaluate bone marrow function and oxygen-carrying capacity of blood.
- Support diagnosis and monitoring of chronic diseases affecting blood production.
- Monitor response to treatments such as iron therapy or chemotherapy.
Symptoms That May Lead to the Test
Doctors may recommend a hematocrit test if you have symptoms such as persistent fatigue, pale skin, shortness of breath, dizziness, rapid heartbeat, excessive bleeding, or signs of dehydration (dry mouth, reduced urine output).
Abnormal Results
Low Hematocrit: Suggests anemia, blood loss, nutritional deficiencies (iron, B12, folate), bone marrow disorders, or chronic illness.
High Hematocrit: May indicate dehydration, polycythemia vera, lung disease, heart disease, or living at high altitudes where oxygen is lower.
Normal Ranges: Typically 38–46% for women and 41–53% for men (values may vary by lab and age group).
Risks
The test involves a routine blood draw. Risks are minimal and include slight bruising, mild pain, or dizziness at the puncture site, which usually resolve quickly.

Reviews
There are no reviews yet.